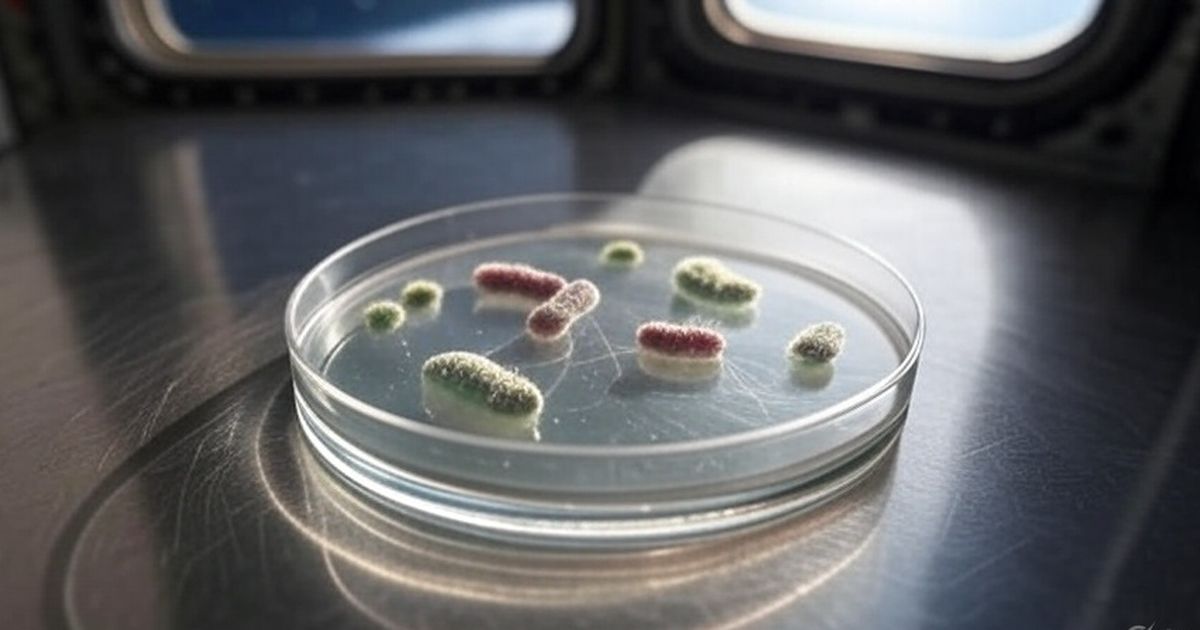
{{caption}}

Ilmuwan Temukan Bakteri Alien di Stasiun Luar Angkasa China, Belum Pernah Ada di Bumi
Bakteri ini punya kemampuan bertahan hidup di kondisi ekstrem.

Ilmuwan baru-baru ini membuat penemuan yang cukup menggemparkan. Mereka menemukan spesies bakteri 'alien' baru di stasiun luar angkasa Tiangong milik China. Bakteri ini diberi nama Niallia tiangongensis.
Hal yang membuat penemuan ini menarik adalah bakteri tersebut belum pernah ditemukan di Bumi. Selain itu, bakteri ini menunjukkan kemampuan unik untuk bertahan hidup dalam kondisi ekstrem ruang angkasa.
Dikutip dari Greek Reporter, Kamis (22/5), bakteri ini ditemukan pada panel kontrol wahana antariksa dan diyakini secara unik beradaptasi dengan kehidupan di luar angkasa. Penemuan ini bagian dari penyelidikan yang lebih luas di bawah Program Mikrobioma Area Hunian Stasiun Luar Angkasa China (CHAMP), yang mempelajari bagaimana mikroba berperilaku di lingkungan tertutup dan berawak selama misi luar angkasa jangka panjang.
Menurut laporan China Central Television, para astronot mengumpulkan sampel usap dari bagian dalam stasiun pada Mei 2023. Sampel tersebut dibekukan dan kemudian dikembalikan ke Bumi untuk dianalisis.
Sebuah studi yang diterbitkan dalam Journal of Systematic and Evolutionary Microbiology merinci bagaimana bakteri tersebut diisolasi dan diurutkan secara genetik. Para peneliti mengonfirmasi bakteri tersebut termasuk dalam genus Niallia, sekelompok bakteri berbentuk batang yang dikenal karena dinding selnya yang tebal dan kemampuannya membentuk endospora—struktur kuat yang memungkinkan mereka bertahan hidup dalam kondisi ekstrem.
Punya Kerabat di Bumi
Niallia tiangongensis memiliki beberapa karakteristik unik yang memungkinkannya bertahan hidup di lingkungan ekstrem luar angkasa. Salah satunya adalah ketahanannya terhadap stres oksidatif. Bakteri ini mampu memperbaiki kerusakan akibat radiasi.
Kemampuan ini sangat penting untuk kelangsungan hidup di lingkungan luar angkasa yang keras. Selain itu, Niallia tiangongensis juga memiliki sumber nutrisi yang unik. Bakteri ini menggunakan gelatin sebagai sumber nitrogen dan karbon.
Hal ini memungkinkan bakteri membentuk lapisan pelindung (biofilm). Lapisan ini melindungi diri dari kondisi lingkungan yang merugikan. Niallia tiangongensis juga memiliki kerabat dekat di Bumi, yaitu Niallia circulans.
Niallia circulans merupakan bakteri yang ditemukan di tanah dan saluran air. Meski begitu, N. tiangongensis menunjukkan perbedaan genetik yang signifikan, yang menegaskan bahwa bakteri 'alien' ini merupakan spesies baru.
Meskipun asal usulnya yang tepat masih belum diketahui, para ahli sedang menyelidiki apakah ia berevolusi di dalam stasiun atau merupakan organisme yang belum ditemukan di Bumi sebelum peluncuran.
Meskipun penemuan ini dianggap sebagai terobosan ilmiah, masih ada pertanyaan tentang potensi dampak bakteri tersebut terhadap kesehatan manusia. Sejauh ini, tidak ada bukti Niallia tiangongensis menimbulkan ancaman bagi astronot. Namun, kerabat terdekatnya di Bumi, Niallia circulans, diketahui menyebabkan infeksi seperti sepsis, terutama pada orang dengan sistem kekebalan tubuh yang lemah.

























:strip_icc():format(webp)/kly-media-production/medias/8261730/original/044268900_1781756195-IMG_3586.jpeg)
:strip_icc():format(webp)/kly-media-production/medias/5574562/original/084743300_1777968071-331fb195-decf-4ad8-9765-83918d262ef7.JPG)
:strip_icc():format(webp)/kly-media-production/medias/8263328/original/010998600_1781883632-40d61759-e5b4-4164-b814-01ba8afee642.jpeg)
:strip_icc():format(webp)/kly-media-production/medias/8263345/original/081855100_1781887842-IMG_20260619_205520.v1.jpg)
:strip_icc():format(webp)/kly-media-production/medias/8263286/original/078037600_1781877229-IMG_4038.jpeg)
:strip_icc():format(webp)/kly-media-production/medias/8263316/original/003749800_1781881522-IMG_4134.jpeg)